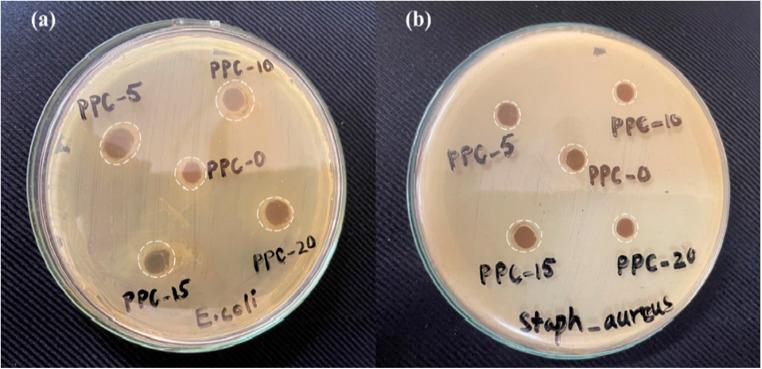
https://cdn.ncbi.nlm.nih.gov/pmc/blobs/a5e0/12377200/b9a6143c3b13/d5ra01989c-f8.jpg

羟基磷灰石增强果胶水凝胶薄膜PEC/PVA/APTES/HAp:用于多西环素负载以实现持续药物释放及伤口愈合应用
Hydroxyapatite-reinforced pectin hydrogel films PEC/PVA/APTES/HAp: doxycycline loading for sustained drug release and wound healing applications.
作者信息
Manzoor Hirra, Arshad Nasima, Ur Rehman Qureshi Muhammad Anees, Javed Aneela
机构信息
Department of Chemistry, Allama Iqbal Open University Islamabad Pakistan
Healthcare Biotechnology, Atta-ur-Rehman School of Applied Biosciences, National University of Sciences & Technology Islamabad Pakistan.
出版信息
RSC Adv. 2025 Aug 22;15(37):30026-30045. doi: 10.1039/d5ra01989c.
Doxycycline (DOXY)-loaded hydroxyapatite (HAp) pectin hydrogel films were prepared for sustained drug release and wound healing application. A series of pectin-based, DOXY-loaded hydrogels were synthesized a solution casting method. HAp at varying amounts was used as a filler to synthesize PEC/PVA/APTES/HAp (PPC-5, -10, -15, -20) hydrogels. SEM, FTIR, TGA, and XRD analyses verified the porous morphology, structural integrity, thermal stability and amorphous nature of the hydrogels, respectively. A biodegradation study of the hydrogel was conducted using phosphate buffer saline (PBS) and proteinase-K enzymatic solutions. Cell viability was evaluated using the MTT assay with HEK293 cells. Moreover, drug-loaded hydrogel dressings were developed and subjected to wound healing studies on albino mice. Excision wound infliction was created to produce a 5-6 mm wide and 2-3 mm deep cutaneous wound. Swelling of the hydrogel films was found to be inversely related to the concentrations of HAp. The hydrogels exhibited significant swelling profiles in distilled water with a maximum swelling of 2519% in 140 min, while the highest swelling was observed at pH 6 in both buffer and non-buffer solutions. Antibacterial studies indicated bactericidal activity of hydrogels against both Gram-positive () and Gram-negative () bacteria. release of DOXY from the hydrogel matrix (PPC-10) revealed 88.57% drug release in PBS solution within 3.5 h. Wound healing studies exhibited exceptional healing tendency, with complete excision wound healing achieved in 8 days. In conclusion, the remarkable biocompatible, biodegradable and nontoxic pectin-based hydrogel systems are suitable for drug delivery, tissue engineering, wound healing, and other medico-biological applications.
制备了载有强力霉素(DOXY)的羟基磷灰石(HAp)果胶水凝胶薄膜,用于药物持续释放和伤口愈合应用。采用溶液浇铸法合成了一系列基于果胶的载DOXY水凝胶。使用不同量的HAp作为填料来合成PEC/PVA/APTES/HAp(PPC - 5、-10、-15、-20)水凝胶。扫描电子显微镜(SEM)、傅里叶变换红外光谱(FTIR)、热重分析(TGA)和X射线衍射(XRD)分析分别证实了水凝胶的多孔形态、结构完整性、热稳定性和无定形性质。使用磷酸盐缓冲盐水(PBS)和蛋白酶K酶溶液对水凝胶进行了生物降解研究。使用MTT法对人胚肾293(HEK293)细胞进行细胞活力评估。此外,开发了载药水凝胶敷料并在白化小鼠上进行伤口愈合研究。通过切除造成伤口,形成一个宽5 - 6毫米、深2 - 3毫米的皮肤伤口。发现水凝胶薄膜的溶胀与HAp的浓度呈负相关。水凝胶在蒸馏水中表现出显著的溶胀特性,在140分钟内最大溶胀率为2519%,而在缓冲溶液和非缓冲溶液中,在pH 6时观察到最高溶胀。抗菌研究表明水凝胶对革兰氏阳性( )和革兰氏阴性( )细菌均具有杀菌活性。DOXY从水凝胶基质(PPC - 10)中的释放显示在3.5小时内PBS溶液中的药物释放率为88.57%。伤口愈合研究显示出优异的愈合趋势,在8天内实现了完全切除伤口愈合。总之,基于果胶的具有显著生物相容性、可生物降解性和无毒的水凝胶系统适用于药物递送、组织工程、伤口愈合和其他医学 - 生物学应用。